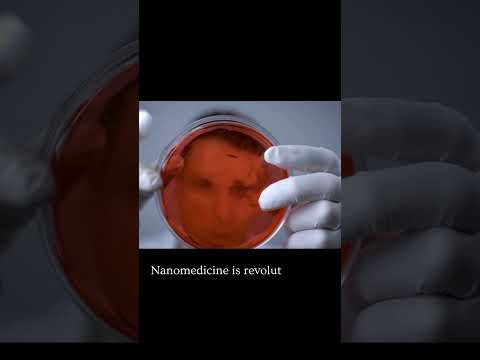

Magzinfo
long covid effects on brain #mri #longcovideffectsonbrain #covideffectsonbrain
0:45

Magzinfo
steam planet GJ9827 #outerspace #planets #space #exoplanets
0:20

Magzinfo
shocking truths about indoor air pollution
3:30

Magzinfo
Revitalise with fresh food #revitalise #naturaldiet #healthydiet #freshfood
0:55
Magzinfo
Nanomedicine The Tiny Tech Making a Big Impact #medical #innovativemedicine #medicine
0:24

Magzinfo
Revolutionizing Impacts of Robot
1:12

Magzinfo
AI in Diagnostics Revolution in Disease Detection #medical #innovativemedicine #aiinhealthcare
0:24

Magzinfo
Engineering and quest for Clean Energy
0:49

Magzinfo
Engineering changing
0:33

Magzinfo
Stem Cell Therapy : Future of Regeneration
0:25

Magzinfo
Regenerative Medicine with Bioengineered Tissues #medicaltechnology #medical #medicine #medicaltech
0:28

Magzinfo
Blockchain beyond crypto
0:42

Magzinfo
Wearable Technology and Continuous Health Monitoring
0:22

Magzinfo
Personalized Medicine Tailoring Treatment to the Individual
0:27

Magzinfo
Global Vaccine Equity and Distribution Challenges
0:27

Magzinfo
Breakthroughs in Cancer Immunotherapy
0:21

Magzinfo
Gene Therapy Milestones From Lab to Clinic
0:20

Magzinfo
Advances in Organ Transplantation Techniques
0:22

Magzinfo
Advances in Mental Health Treatment
0:25

Magzinfo
ai powered drug
0:29

Magzinfo
mRNA Vaccines A New Era in Immunization
0:24

Magzinfo
CRISPER gene editing
0:25